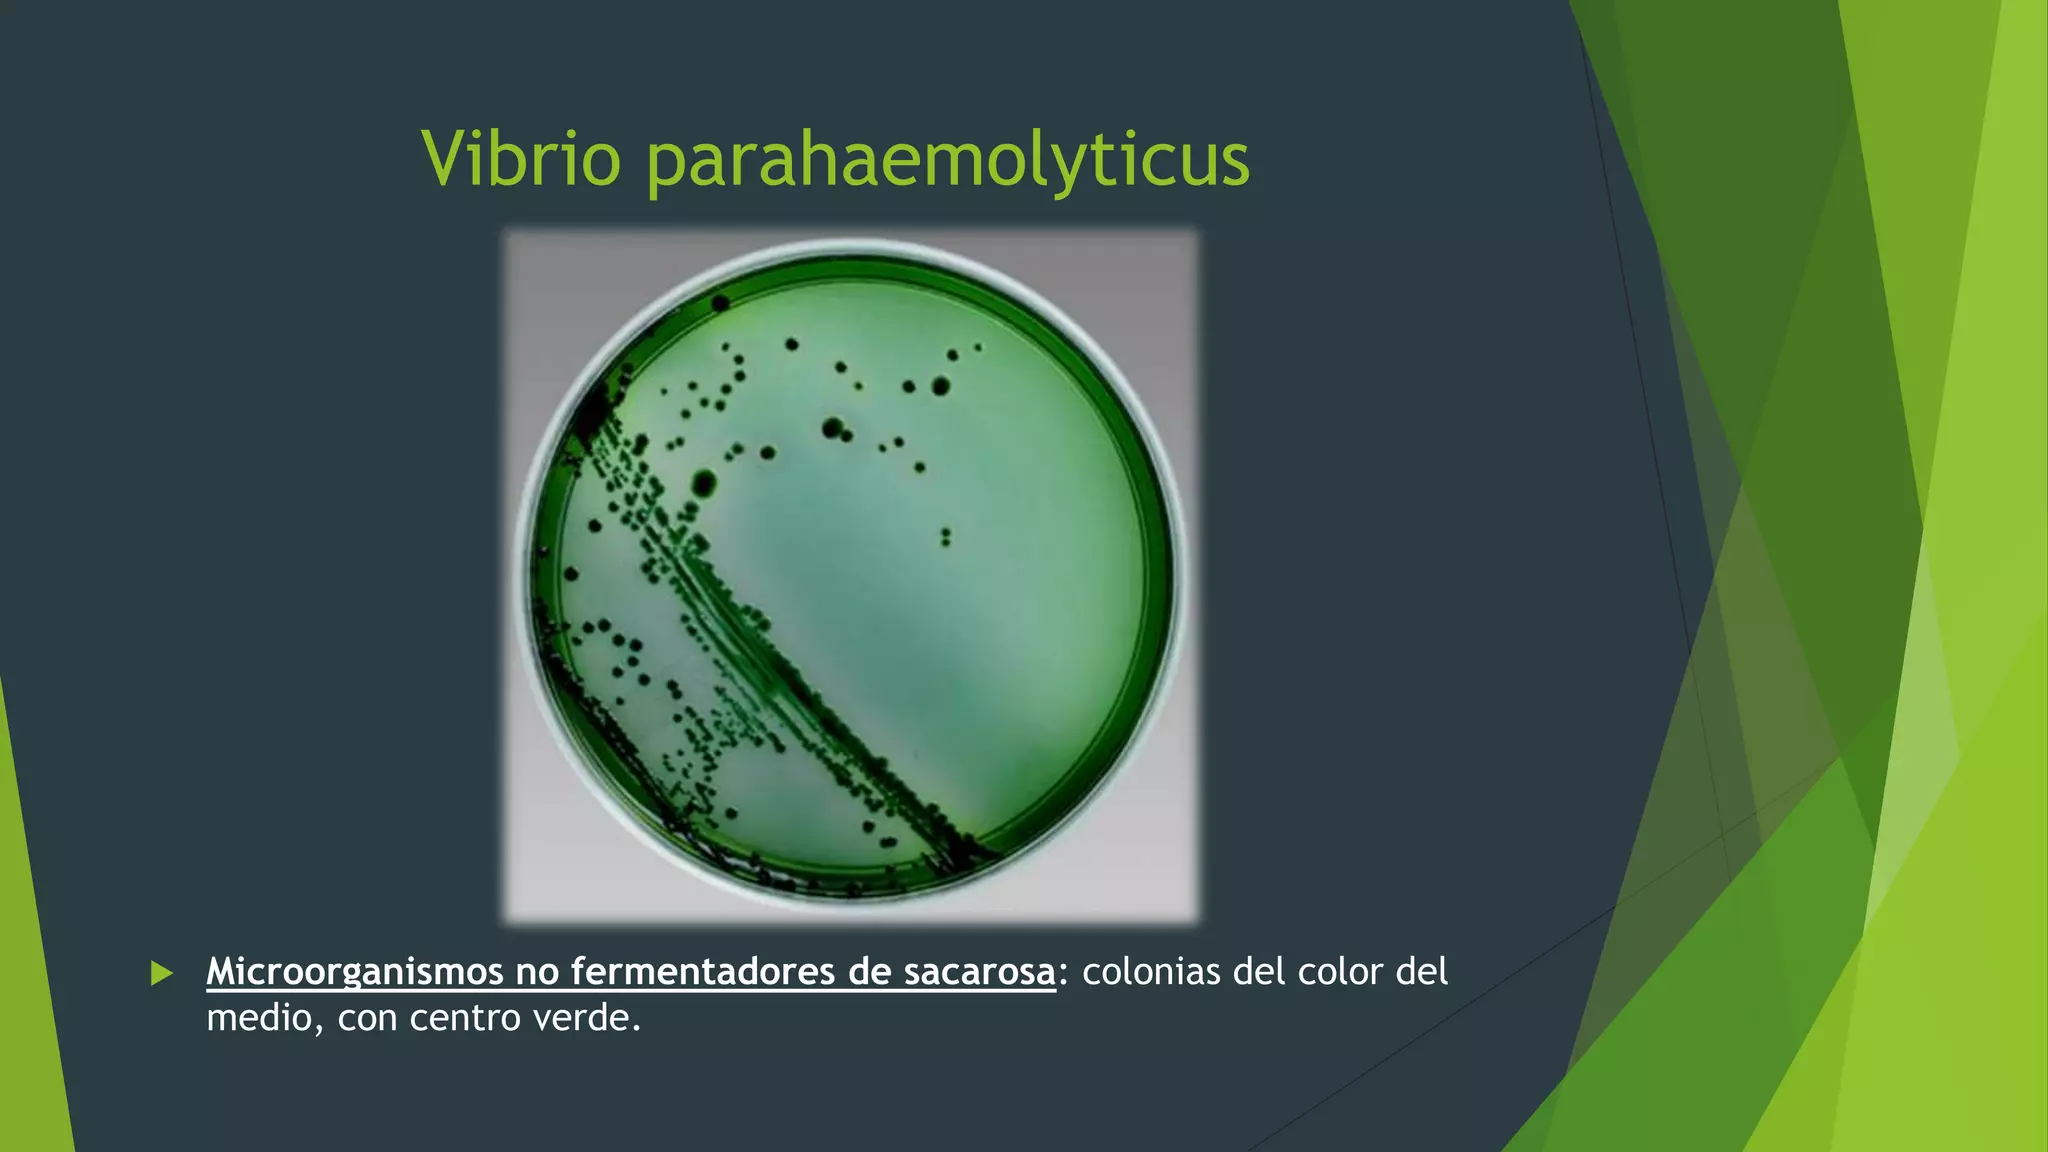
Vibrio parahaemolyticus
 Microorganismos no fermentadores de sacarosa: colonias del color del
medio, con centro verde.

El agar tiosulfato citrato bilis sacarosa (t.c.b.s.) es un medio selectivo y diferencial diseñado para el aislamiento de diversas especies de Vibrio, especialmente V. cholerae, V. parahemolyticus y V. vulnificus, a partir de muestras fecales y alimentarias. Este medio fomenta el crecimiento de Vibrio al inhibir la flora acompañante y utiliza indicadores de pH para la identificación de las colonias. Existen limitaciones en su uso, como la posibilidad de resultados falsos negativos y la necesidad de confirmación con otros medios de cultivo.